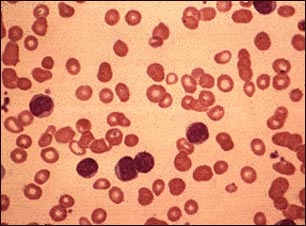
Leucemia linfoc&iacute;tica cr&oacute;nica; vista microsc&oacute;pica

![]() | ![]() | ![]() |
Leucemia linfocítica crónica; vista microscópica
Esta es la apariencia microscópica de la médula ósea de una persona que padece leucemia linfocítica crónica. Se pueden apreciar predominantemente los linfocitos inmaduros y pequeños.
Actualizado: 7/11/2008
